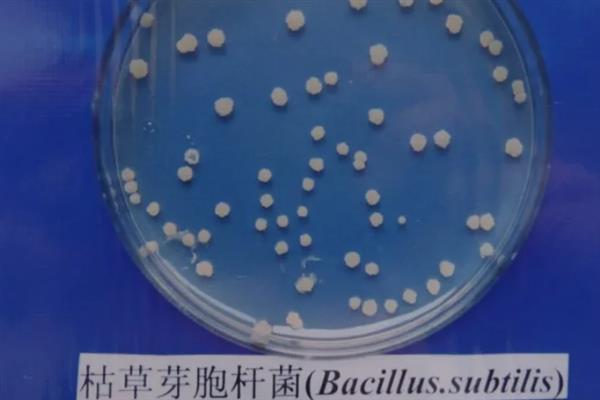
枯草芽孢杆菌的用法用量，可用于拌种、种子包衣等

枯草芽孢杆菌的用法用量,可用于拌种、种子包衣等
鲜果花2025-01-06 10:14:39
拌种:枯草芽孢杆菌拌棉花种对防治黄萎病效果好,如果按1:10-15比例拌种,再配药剂喷雾药效好。
种子包衣:水稻种子包衣能降多种病害发病率,刺激生长增产,可用悬浮剂按1:40比例包衣。
喷雾:防草莓、黄瓜灰霉白粉病要早喷药,并隔7-10天连喷2-3次,再按照一定剂量调配。
灌根:防治番茄青枯病宜用药液灌根,发病初每隔10-15天灌2-3次,按法操作

一、枯草芽孢杆菌的用法用量
1、拌种
使用枯草芽孢杆菌拌棉花种子,对防治黄萎病有非常好的效果,一般使用10亿活芽孢/克可湿性粉剂,可按照1:10-15药种比例进行拌种,生长阶段配合相同的药剂喷雾防效更佳。

2、种子包衣
水稻种子包衣之后,可以减少恶苗病、白叶枯病、细菌性条斑病的发病率,而且还具有刺激植株生长发育、增产增收的效果,一般使用1万活芽孢/毫升悬浮种衣剂,按照1:40的药种比例种子包衣。

3、喷雾
防治草莓与黄瓜灰霉病、白粉病,可选择从病害发生早期开始喷药,每隔7-10天喷1次,需要连续喷2-3次,每亩使用1000亿活芽孢/克可湿性粉剂50-60克,兑水30-60升均匀喷雾,或者使用10亿活芽孢/克可湿性粉剂600-800倍液均匀喷雾,防治棉花黄萎病,每亩使用1亿活茅孢/克可湿性粉剂75-100克,兑水30-45升均匀喷雾。

4、灌根
防治番茄青枯病,可选择采用药液灌根的方式灌药,从发病早期阶段开始灌药,每隔10-15天灌1次,需要连续灌2-3次,一般使用10亿活芽孢/克可湿性粉剂600-800倍液灌根,可沿着茎基部向下浇灌,每株浇灌药液用量为150-250毫升。

二、枯草芽孢杆菌灌根用量
1、枯草芽孢杆菌在大棚作物或者蔬菜苗期每袋兑水60公斤,叶面均匀喷洒或灌根,生长期和中后期每袋兑水30公斤叶面均匀喷洒或者灌根。
2、建议在早上10点前或下午4点后施药,防止阳光直射,杀死芽孢,尤其是在下午4点后用药,夜间潮湿的环境有助于芽孢萌发。
3、注意:不可与杀菌剂、抗生素、强酸、强碱类药物同时使用。
声明本文由作者上传并发布,种养业网仅提供信息发布平台,文章仅代表作者个人观点,不代表种养业网立场,内容旨在传播知识,若有内容错误或侵权等问题请及时与本网站联系,我们将在第一时间作更正或删除处理。


